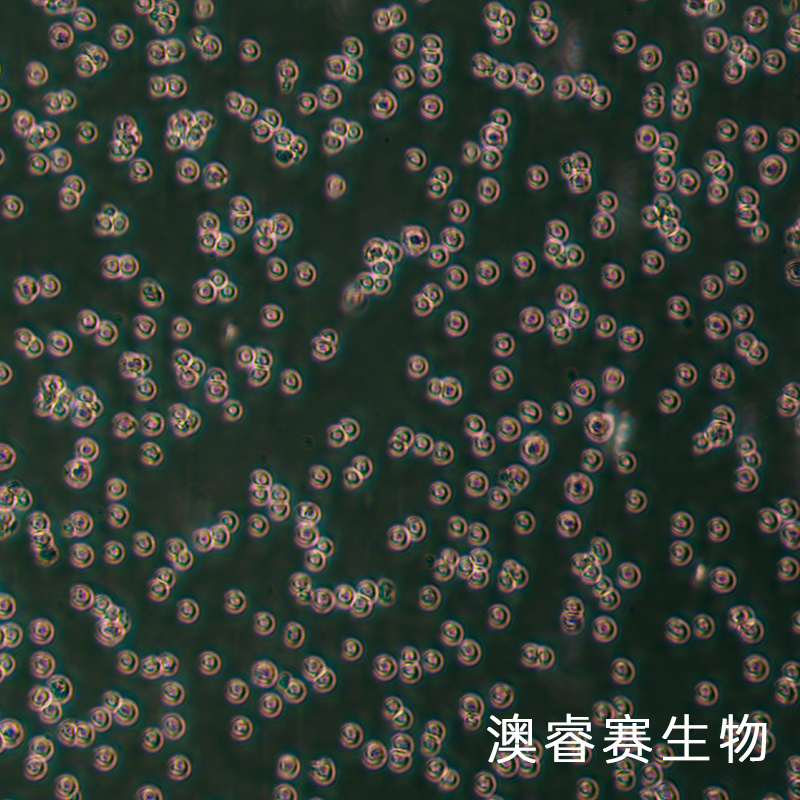
REC-1（人淋巴瘤细胞（B细胞非霍奇金淋巴瘤））

REC-1(人淋巴瘤细胞(B细胞非霍奇金淋巴瘤))
REC-1
¥1680
≥1株
起订
上海 更新日期:2026-04-08
产品详情:
- 中文名称:
- REC-1(人淋巴瘤细胞(B细胞非霍奇金淋巴瘤))
- 英文名称:
- REC-1
- 品牌:
- 澳睿赛生物
- 产地:
- 上海
- 保存条件:
- 气相:95%空气+5%二氧化碳;温度:37℃
- 纯度规格:
- ≥99%
- 产品类别:
- 细胞系 人细胞系
- 种属:
- 人
- 组织:
- 淋巴
- 细胞系:
- 人
- 细胞形态:
- 上皮细胞样
- 生长状态:
- 悬浮生长
公司简介
澳培赛生物科技(上海)有限公司坐落于松江生命科学产业园,是一家专注于细胞生物学领域新产品、新技术开发的技术企业。公司产品涵盖:细胞系、原代细胞、标记细胞、耐药细胞、免疫细胞及胎牛血清、培养基、胰酶、双抗、无血清冷冻液、支原体/黑胶虫清除剂、细胞因子等产品,提供细胞形态和免疫相关检测、流式细胞检测 、细胞学服务、分子生物学检测等多种技术服务。追求细胞行业标准的引领者,澳睿赛始终致力于为您的细胞研究及细胞培养实验提供高品质、稳定性良好的产品。
| 成立日期 | (5年) |
| 注册资本 | 100万人民币 |
| 员工人数 | 1-10人 |
| 年营业额 | ¥ 100万以内 |
| 经营模式 | 试剂,定制,服务 |
| 主营行业 | 生物化工 |
REC-1(人淋巴瘤细胞(B细胞非霍奇金淋巴瘤))相关厂家报价 更多
-

- REC-1 人淋巴瘤细胞系
- 上海宾穗生物科技有限公司 VIP
- 2026-04-08
- 询价
-

- REC-1人淋巴瘤复苏细胞(附STR鉴定报告)
- 上海冠导生物工程有限公司 VIP
- 2026-04-08
- 询价
-

- REC-1人淋巴瘤细胞
- 上海雅吉生物科技有限公司 VIP
- 2026-04-08
- ¥1800
-

- 人套细胞淋巴瘤细胞REC1,ATCC来源
- 上海晶风生物科技有限公司 VIP
- 2026-04-08
- ¥2500
-

- REC-1人淋巴癌细胞
- 上海抚生实业有限公司 VIP
- 2026-04-08
- ¥8800
-

- REC-1人淋巴癌细胞
- 上海博湖生物科技有限公司 VIP
- 2026-04-08
- ¥8800
-

- REC1人淋巴癌细胞
- 上海西格生物科技有限公司 VIP
- 2026-04-08
- ¥16800
-

- REC-1(人淋巴瘤细胞(B细胞非霍奇金淋巴瘤))YB-71716HC
- 上海钰博生物科技有限公司 VIP
- 2026-03-26
- ¥1512
-

- REC-1细胞(人淋巴瘤细胞(B细胞非霍奇金淋巴瘤))LM8C1423
- 上海联迈生物工程有限公司 VIP
- 2026-01-28
- ¥1680
-

- REC-1人非霍奇金淋巴瘤细胞库|培养基|带STR图谱
- 上海宾穗生物科技有限公司
- 2025-12-31
- 询价